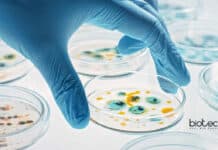
IISER TVM Biotech & Biological Sciences Research Fellow Job Opening IISER TVM

RGCB Neural Stem Cells Project JRF For Life Sciences, Apply Online
RGCB JRF Project Job - Life Sciences Apply Online
RGCB JRF Project Job - Life Sciences Apply Online. RGCB, Thiruvananthapuram is hiring MSc candidates. Life...
MSD Biological Sciences Regulatory Affairs Specialist Recruitment
MSD Biological Sciences Regulatory Affairs Specialist Recruitment
MSD Biological Sciences Regulatory Affairs Specialist Recruitment. Biological Sciences candidates apply for a Regulatory Affairs Specialist position that...
CSIR-IMTECH Biotech R&D Project Recruitment, Apply Online
IMTECH Biotech R&D Project Recruitment, Apply Online
IMTECH Biotech R&D Project Recruitment, Apply Online. Project Associate II Recruitment. MSc Microbiology or Biotechnology. MTech Biotechnology/microbial biotechnology...
Chittaranjan National Cancer Institute Life Sciences Junior Research Fellows Recruitment
CNCI Life Sciences JRF - Applications Invited
CNCI Life Sciences JRF - Applications Invited. Chittaranjan National Cancer Institute Jobs. MSc Life Science & Biophysics Jobs....
JNCASR R&D Assistant Recruitment – Applications Invited
JNCASR R&D Assistant Recruitment - Applications Invited
JNCASR R&D Assistant Recruitment - Applications Invited. MSc/ MTech Biological Sciences Jobs. R&D Assistant Vacancy. Interested applicants can...
ICAR PDF Fellowships 2021-22 – Rs. 75,000/- pm + Rs 2 Lakh Research Grant
ICAR PDF Fellowships 2021-22 - Rs. 75,000/- pm + Rs 2 Lakh Grant
ICAR PDF Fellowships 2021-22 - Rs. 75,000/- pm + Rs 2 Lakh...
IISER TVM Biotech & Biological Sciences Research Fellow Job Opening
IISER TVM Biological Sciences & Biotech Research Fellow Job Opening
IISER TVM Biological Sciences & Biotech Research Fellow Job Opening. IISER TVM is hiring Biological...
Govt ILS Research Fellow Recruitment – Virus & Innate Immunity Project
ILS Bhubaneswar JRF Recruitment - Applications Invited
ILS Bhubaneswar JRF Recruitment - Applications Invited. Institute of Life Sciences (ILS), Bhubaneswar is hiring M.Sc. Life Sciences...
Training Course On ‘Methods in Cancer Biology Research’ at St John’s Research Institute
SJRI Training Course - Methods in Cancer Biology Research
The St John’s Research Institute ( at the St John’s National Academy of Health Sciences
(part of...
Dept of Genetics – Delhi University Research Fellow Recruitment
Delhi University Life Science SRF Job Available
Delhi University Life Science SRF Job Available. The University of Delhi is hiring for research positions. Senior Research...
DBT/ Wellcome Trust India Alliance: Early Career Fellowships In Basic Biomedical Research
Early Career Fellowships In Basic Biomedical Research - Call For Applications
Early Career Fellowships In Basic Biomedical Research - Call For Applications. DBT/ Wellcome Trust...
Project Student Intern Recruitment at ICAR-IARI For Life Sciences
Project Student Intern Recruitment at ICAR-IARI For Life Sciences
Project Student Intern Recruitment at ICAR-IARI For Life Sciences. MSc Life Sciences / Agriculture with specializations...
Biotecnika Times – Newsletter 03.08.2021 – GATE 2022 Exam, Govt Ministry of Earth Sciences
Biotecnika Times - GATE 2022 Exam, Govt Ministry of Earth Sciences
GATE 2022 Exam Official Notification, Application Date, Deadline & Eligibility
GATE 2022 Official Notification, Application...
Tata Medical Center & Intas Pharma Ltd. Biotech Project Manager Recruitment
Tata Medical Center Biotech Project Manager - Applications Invited
Tata Medical Center Biotech Project Manager - Applications Invited. Tata Translational Cancer Research Center Recruitment MSc...
Top 10 Most Popular Courses at Biotecnika – Best Selling Biotech / Life Science...
Top Biotecnika Certification Courses - 10 Best Selling Biotech & Life Sciences
In this video, we will talk about the Top Biotecnika Certification Courses and...